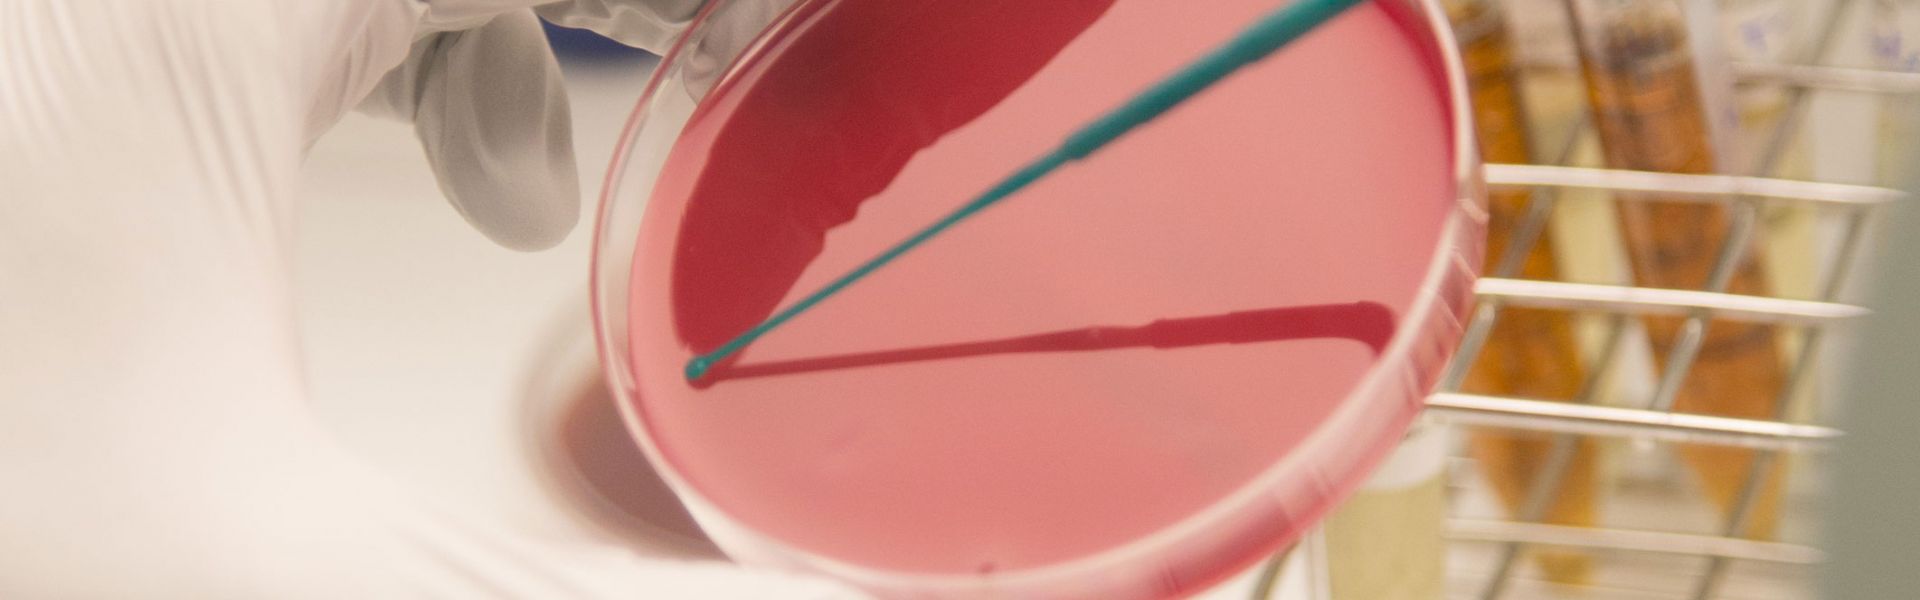

Résistance aux antibiotiques : de nouveaux éléments concernant la colistine
La colistine est un antibiotique utilisé en médecine vétérinaire, notamment pour le traitement d’infections colibacillaires dans les filières animales de production.
En médecine humaine, la colistine a longtemps été écartée des protocoles de soins en raison de sa toxicité, en particulier rénale. Depuis la dissémination mondiale des résistances aux céphalosporines de dernière génération et aux carbapénèmes, la colistine est redevenue un antibiotique prescrit pour le traitement d’infections humaines sévères liées à des bactéries résistantes à toutes les autres options thérapeutiques.
Compte-tenu du recours à la colistine en médecine humaine, la communauté scientifique et médicale s’est interrogée sur le risque de sélection de résistances à la colistine chez l’Homme suite à son usage chez l’animal. Des avis récents ont été formulés, notamment par l’Agence Européenne du Médicament (EMA) et par l’Anses, ne recommandant pas, à ce stade des connaissances, d’inclure la colistine dans la liste des antibiotiques critiques utilisés en médecine vétérinaire, et dont l’usage doit être encadré. En particulier, l’absence de mécanisme de résistance à la colistine transférable entre bactéries constituait un argument scientifique fort.
Novembre 2015 : description du premier mécanisme de résistance à la colistine transférable
Le 18 novembre 2015, le premier mécanisme de résistance à la colistine transférable (le gène mcr-1) a été décrit en Chine chez des porcs et des poulets, à partir de viande vendue au détail, ainsi que chez des souches bactériennes isolées chez l’Homme1. La prévalence de ce gène plasmidique a été estimée à environ 20% chez l’animal et autour de 1% chez l’Homme.
La publication de la séquence génétique du gène mcr-1 a conduit plusieurs instituts à rechercher sa présence dans d’autres collections bactériennes à l’échelle mondiale. A ce jour, en Europe, le gène mcr-1 a été détecté dans des souches bactériennes d’Escherichia coli et/ou de Salmonella enterica, par le Laboratoire de Référence européen sur l’antibiorésistance animale (DTU, Danemark)2, par le Laboratoire de Référence en Santé Publique en Angleterre3 et par les quatre laboratoires de l’Anses impliqués dans la surveillance de l’antibiorésistance animale4. Dans toutes ces collections, la prévalence du gène mcr-1 est particulièrement faible.
Par ailleurs, aucune augmentation alarmante de la résistance à la colistine des bactéries isolées des filières avicole et porcine n’a été enregistrée par les différents réseaux de surveillance de l’Anses au cours des dernières années.
Le 17 décembre 2015, des données complémentaires sur la distribution du gène mcr-1 dans d’autres collections mondiales ont été publiées4, 5, 6, 7, 8. Elles confirment une faible prévalence de ce gène chez l’Homme et fournissent des éléments moléculaires additionnels.
De nombreux travaux sont en cours sur ce sujet, et plusieurs questions persistent à ce jour. Elles concernent notamment:
- la prévalence du gène mcr-1 dans les différents secteurs, animaux et humains, en France, en Europe et dans le monde. Les différents échantillonnages des collections bactériennes étudiées permettent de conclure à la détection de ce gène, et non encore à des niveaux de prévalence validés sur un plan épidémiologique ;
- l’ancienneté de la dissémination du gène mcr-1 dans les flores bactériennes animales et humaines. La plupart des données publiées concernent des souches plutôt récentes (> 2010). Sa plus ou moins grande ancienneté dans les filières animales est un élément d’appréciation important dans l’analyse de risque ;
- les niveaux de résistance à la colistine (faible ou élevé) des bactéries possédant le gène mcr-1, dont l’impact thérapeutique est directement dépendant. Egalement, le gène mcr-1 n’est pas présent dans toutes les bactéries résistantes à la colistine, ce qui pose la question de la part de ce mécanisme dans l’explication plus large de cette résistance ;
- les possibilités (ou non) de co-sélection du gène mcr-1 par l’usage d’autres antibiotiques que la colistine, tels que ceux largement utilisés en médecine vétérinaire (tétracyclines, sulfamides) ou ceux d’importance critique pour l’Homme et à dissémination plasmidique (céphalosporines de dernières générations) ;
- la diversité des caractéristiques moléculaires des supports génétiques (types de plasmides) et des clones bactériens porteurs du gène mcr-1, dont dépendent les capacités plus ou moins fortes de diffusion entre espèces bactériennes, entre espèces animales et de l’animal à l’Homme.
Une nouvelle analyse des risques liés à l’usage de la colistine nécessaire
Les éléments scientifiques récemment identifiés sur la résistance bactérienne à la colistine devront être pris en compte dans une nouvelle analyse des risques liés à l’usage de la colistine, notamment en médecine vétérinaire.
Dans ce contexte, l’EMA souhaite réunir de nouveau le groupe d’experts ad hoc sur l’antibiorésistance (AMEG) afin de réviser l’avis publié en 2013 relatif à l’usage de la colistine en médecine vétérinaire. Des experts de l’Anses font partie de ce groupe ad hoc.
Depuis de nombreuses années, l’Anses joue un rôle clé de surveillance et d’alerte concernant les phénomènes d’antibiorésistance dans le monde animal, et en lien avec les conséquences possibles en Santé publique. Ce travail est réalisé grâce à la réactivité de l’ensemble des dispositifs qu’elle pilote, de surveillance réglementaire à l’abattoir et dans les aliments, et dans le cadre de l’activité des réseaux Salmonella et Résapath mis en place depuis plusieurs dizaines d’années en France. En parallèle, l’Anses-ANMV, par son implication auprès de l’EMA et son suivi annuel des consommations d’antibiotiques vétérinaires, fournit des éléments essentiels sur l’exposition des animaux aux antibiotiques, qui sont utilement mis en regard avec les niveaux de résistance observés.
L’Anses révisera en conséquence l’évaluation du risque conduite dans son avis scientifique (avis n° 2015-SA-0118) (PDF) sur le classement de la colistine en tant qu’antibiotique vétérinaire d’importance critique.
Références
- Liu et al. Emergence of plasmid-mediated colistin resistance mechanism MCR-1 in animals and human beings in China: a microbiological and molecular biological study. Lancet Infect Dis 2015; published online Nov 18. dx.doi.org/10.1016/S1473-3099(15)00424-7
- Hasman et al. Detection of mcr-1 encoding plasmid-mediated colistin-resistant Escherichia coli isolates from human bloodstream infection and imported chicken meat, Denmark 2015. Eurosurveillance 2015; published online Dec 10. dx.doi.org/10.2807/15607917.ES.2015.20.49.30085
- Public Health England (PHE). First detection of plasmid-mediated colistin resistance (mcr-1 gene) in food and human isolates in England and Wales (Serial number 2015/090). London: Public Health England, 2015.
- Webb et al. Dissemination of the mcr-1 colistin resistance gene.Lancet Infect Dis2015; published online Dec 17, 2015. dx.doi.org/10.1016/S1473-3099(15)00538-1
- Arcilla et al. Dissemination of the mcr-1 colistin resistance gene.Lancet Infect Dis2015; published online Dec 17, 2015. dx.doi.org/10.1016/S1473-3099(15)00541-1
- Hu et al. Dissemination of the mcr-1 colistin resistance gene.Lancet Infect Dis2015; published online Dec 17, 2015. dx.doi.org/10.1016/S1473-3099(15)00533-2
- Olaitan et al. Dissemination of the mcr-1 colistin resistance gene.Lancet Infect Dis2015; published online Dec 17, 2015. dx.doi.org/10.1016/S1473-3099(15)00540-X
- Tse et al. Dissemination of the mcr-1 colistin resistance gene.Lancet Infect Dis2015; published online Dec 17, 2015. dx.doi.org/10.1016/S1473-3099(15)00532-0


